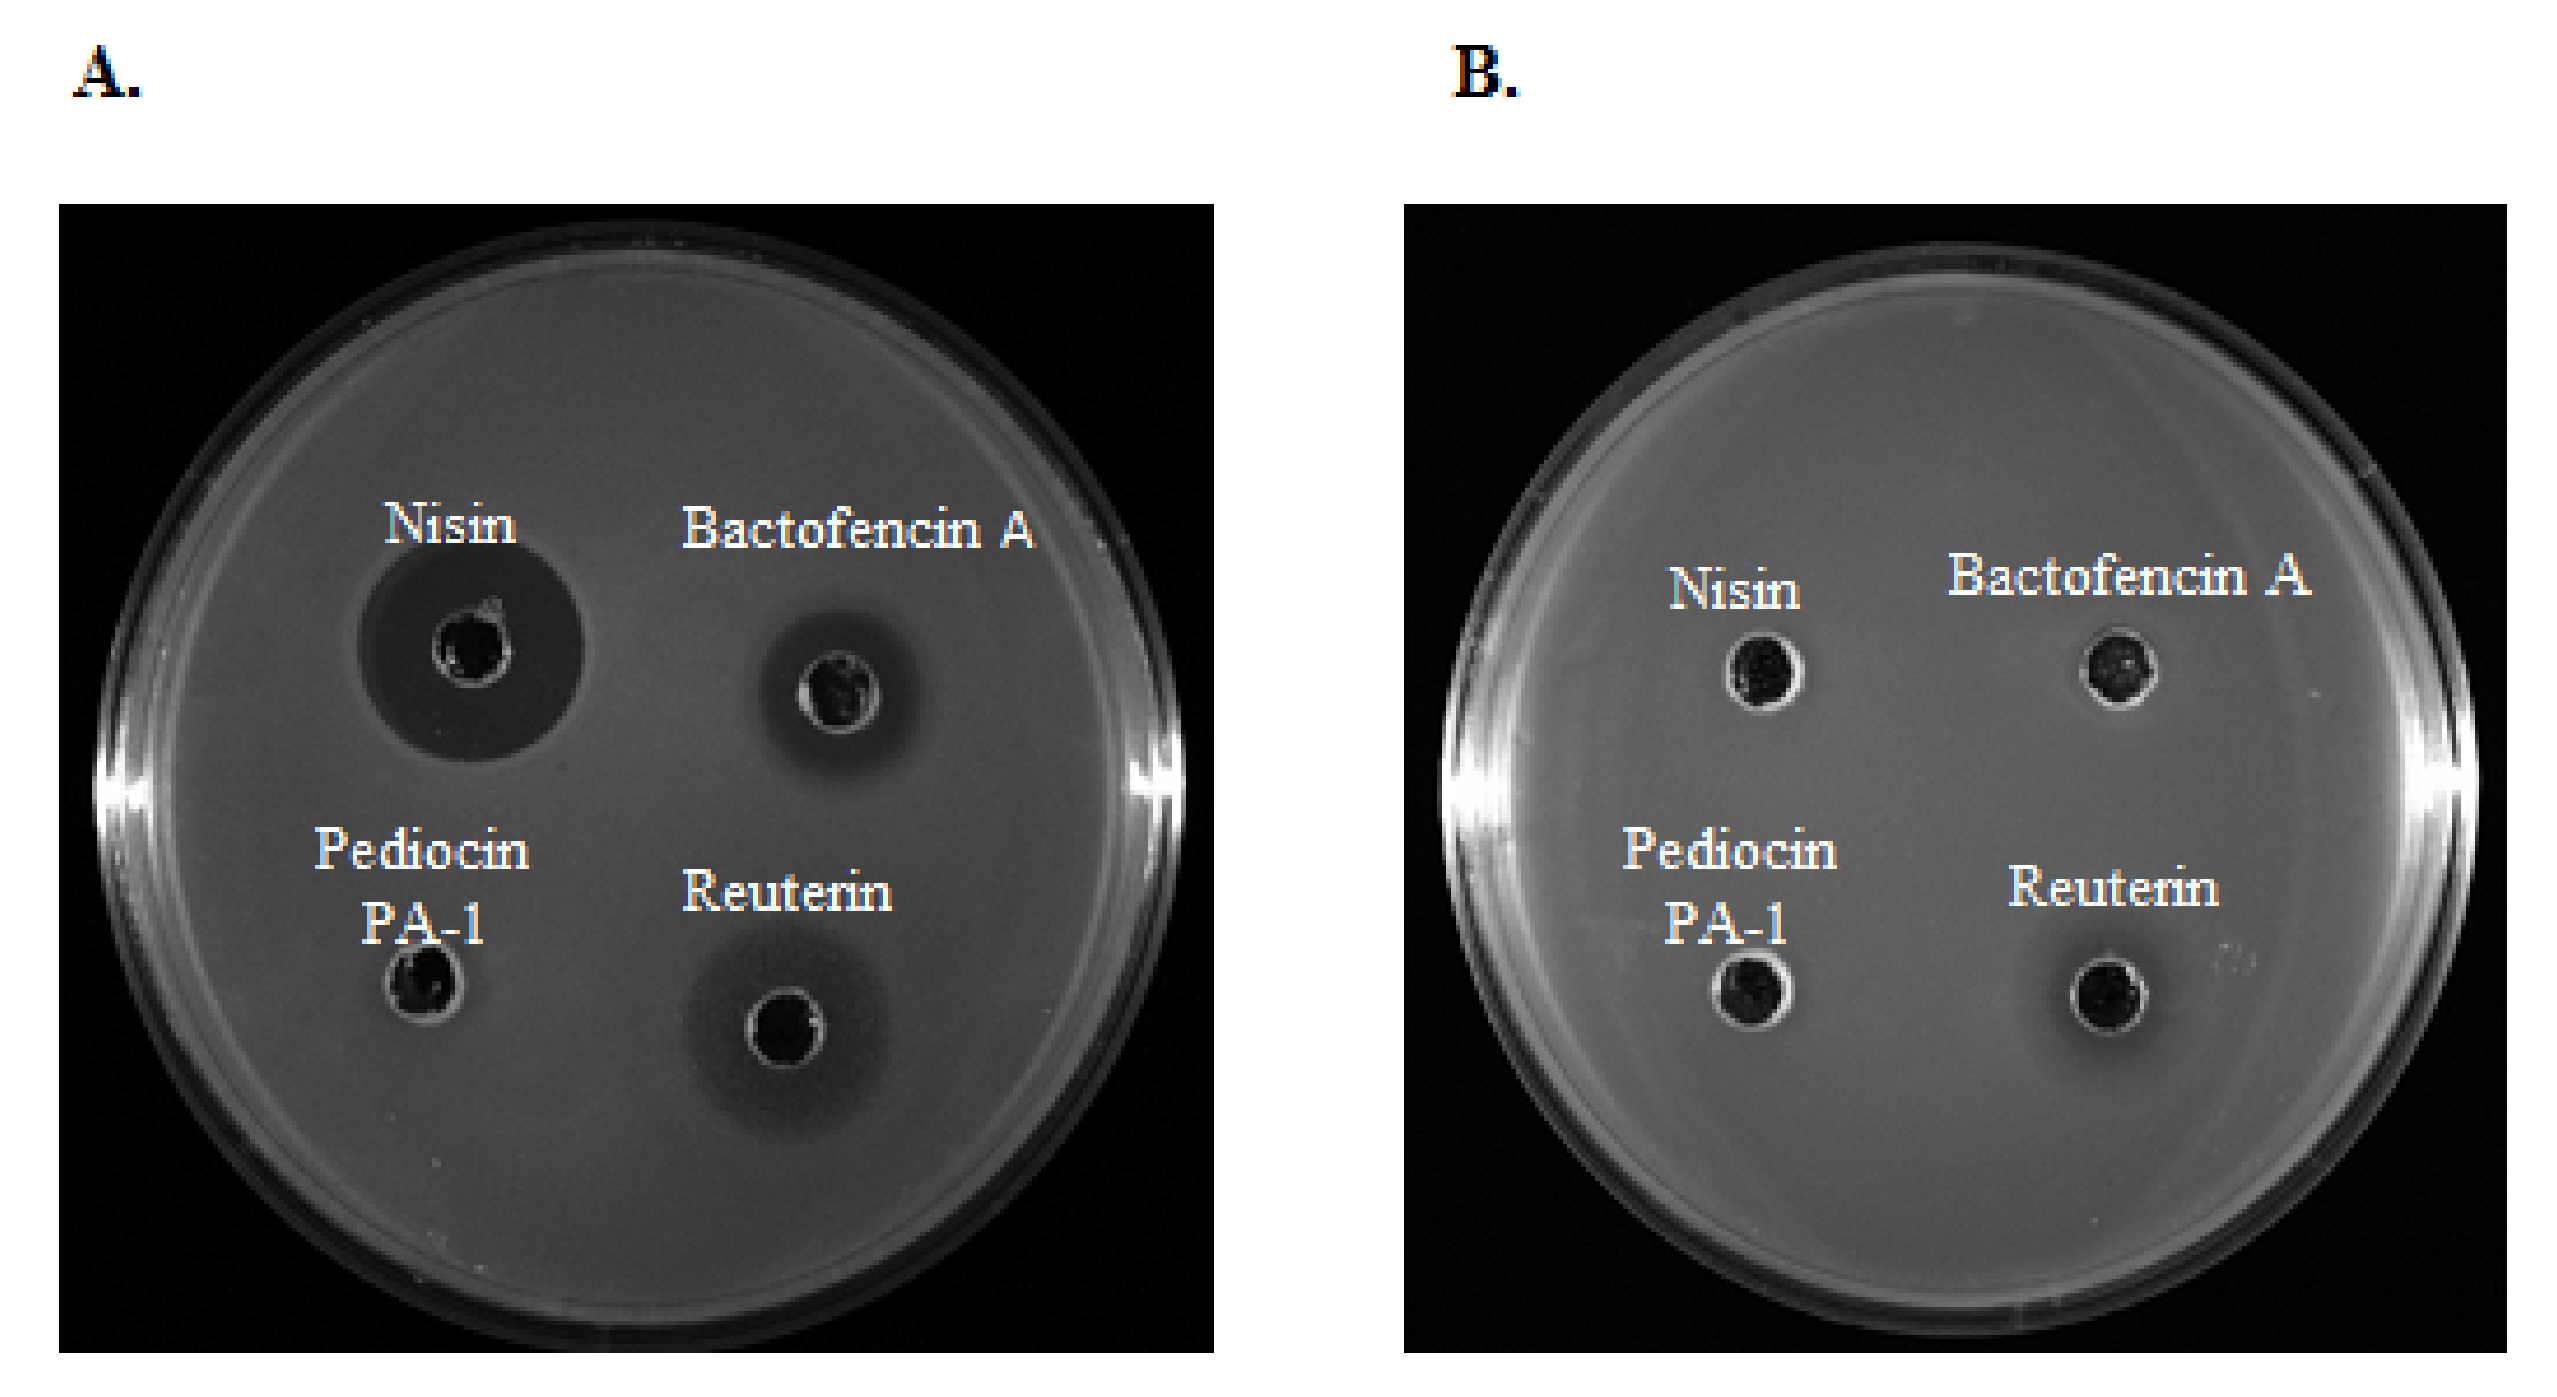
Antibiotics 10 01418 g002

Susceptibility to Nisin, Bactofencin, Pediocin and Reuterin of Multidrug Resistant Staphylococcus aureus, Streptococcus dysgalactiae and Streptococcus uberis Causing Bovine Mastitis
Abstract
:1. Introduction
2. Results and Discussions
2.1. Antimicrobial Compound Production and Purification
2.2. Antibiotic Susceptibility Profiles
2.3. Antimicrobial Activity
2.3.1. Antimicrobial Activity of Nisin
2.3.2. Antimicrobial Activity of Reuterin
2.3.3. Antimicrobial Activity of Bactofencin A
2.3.4. Antimicrobial Activity of Pediocin
3. Materials and Methods
3.1. Bacterial Strains
3.2. Antimicrobial Compound Production and Purification
3.3. Antibiotic Susceptibility Testing
3.4. Minimum Inhibitory and Bactericidal Concentrations
4. Conclusions
Author Contributions
Funding
Institutional Review Board Statement
Informed Consent Statement
Data Availability Statement
Acknowledgments
Conflicts of Interest
References
- Centers for Disease Control and Prevention. Antibiotic/Antimicrobial Resistance. 20 July 2020. Available online: https://www.cdc.gov/drugresistance/index.html (accessed on 3 November 2021).
- Watkins, R.R.; Bonomo, R.A. Overview: Global and local impact of antibiotic resistance. Infect. Dis. Clin. N. Am. 2016, 30, 313–322. [Google Scholar] [CrossRef]
- Rice, L.B. Federal funding for the study of antimicrobial resistance in nosocomial pathogens: No eskape. J. Infect. Dis. 2008, 197, 1079–1081. [Google Scholar] [CrossRef] [PubMed]
- Sears, D.; Schwartz, B.S. Candida auris: An emerging multidrug-resistant pathogen. Int. J. Infect. Dis. 2017, 63, 95–98. [Google Scholar] [CrossRef] [PubMed] [Green Version]
- Ventola, C.L. The antibiotic resistance crisis: Part 1: Causes and threats. Pharm. Ther. 2015, 40, 277–283. [Google Scholar]
- Michael, C.A.; Dominey-Howes, D.; Labbate, M. The antimicrobial resistance crisis: Causes, consequences, and management. Public Health Front. 2014, 2, 145. [Google Scholar] [CrossRef] [PubMed]
- Silbergeld, E.K.; Graham, J.; Price, L.B. Industrial food animal production, antimicrobial resistance, and human health. Annu. Rev. Public Health 2008, 29, 151–169. [Google Scholar] [CrossRef] [PubMed]
- Petrovski, K.R.; Grinberg, A.; Williamson, N.B.; Abdalla, M.E.; Lopez-Villalobos, N.; Parkinson, T.J.; Tucker, I.G.; Rapnicki, P. Susceptibility to antimicrobials of mastitis-causing Staphylococcus aureus, Streptococcus uberis and Str. dysgalactiae from new zealand and the USA as assessed by the disk diffusion test. Aust. Vet. J. 2015, 93, 227–233. [Google Scholar] [CrossRef]
- Halasa, T.; Huijps, K.; Osteras, O.; Hogeveen, H. Economic effects of bovine mastitis and mastitis management: A review. Vet. Q. 2007, 29, 18–31. [Google Scholar] [CrossRef] [PubMed]
- Rollin, E.; Dhuyvetter, K.C.; Overton, M.W. The cost of clinical mastitis in the first 30 days of lactation: An economic modeling tool. Prev. Vet. Med. 2015, 122, 257–264. [Google Scholar] [CrossRef] [PubMed] [Green Version]
- Aghamohammadi, M.; Haine, D.; Kelton, D.F.; Barkema, H.W.; Hogeveen, H.; Keefe, G.P.; Dufour, S. Herd-level mastitis-associated costs on canadian dairy farms. Front. Vet. Sci. 2018, 5, 100. [Google Scholar] [CrossRef]
- Chikindas, M.L.; Weeks, R.; Drider, D.; Chistyakov, V.A.; Dicks, L.M. Functions and emerging applications of bacteriocins. Curr. Opin. Biotechnol. 2018, 49, 23–28. [Google Scholar] [CrossRef]
- Cotter, P.D.; Hill, C.; Ross, R.P. Bacteriocins: Developing innate immunity for food. Nat. Rev. Microbiol. 2005, 3, 777–788. [Google Scholar] [CrossRef] [PubMed]
- Hammami, R.; Zouhir, A.; Le Lay, C.; Ben Hamida, J.; Fliss, I. Bactibase second release: A database and tool platform for bacteriocin characterization. BMC Microbiol. 2010, 10, 22. [Google Scholar] [CrossRef] [PubMed] [Green Version]
- Pieterse, R.; Todorov, S.D. Bacteriocins-exploring alternatives to antibiotics in mastitis treatment. Braz. J. Microbiol. 2010, 41, 542–562. [Google Scholar] [CrossRef] [PubMed] [Green Version]
- Shin, J.M.; Gwak, J.W.; Kamarajan, P.; Fenno, J.C.; Rickard, A.H.; Kapila, Y.L. Biomedical applications of nisin. J. Appl. Microbiol. 2016, 120, 1449–1465. [Google Scholar] [CrossRef] [PubMed] [Green Version]
- Ahmad, V.; Khan, M.S.; Jamal, Q.M.S.; Alzohairy, M.A.; Al Karaawi, M.A.; Siddiqui, M.U. Antimicrobial potential of bacteriocins: In therapy, agriculture and food preservation. Int. J. Antimicrob. 2017, 49, 1–11. [Google Scholar] [CrossRef] [PubMed]
- Arqués, J.L.; Rodríguez, E.; Nuñez, M.; Medina, M. Antimicrobial activity of nisin, reuterin, and the lactoperoxidase system on Listeria monocytogenes and Staphylococcus aureus in cuajada, a semisolid dairy product manufactured in Spain. J. Dairy Sci. 2008, 91, 70–75. [Google Scholar] [CrossRef] [PubMed] [Green Version]
- Arqués, J.L.; Rodríguez, E.; Nuñez, M.; Medina, M. Combined effect of reuterin and lactic acid bacteria bacteriocins on the inactivation of food-borne pathogens in milk. Food Control 2011, 22, 457–461. [Google Scholar] [CrossRef]
- Kumar, N.; Kumar, V.; Waheed, S.M.; Pradhan, D. Efficacy of Reuterin and Bacteriocins Nisin and Pediocin in the Preservation of Raw Milk from Dairy Farms. Food Technol. Biotechnol. 2020, 58, 359–369. [Google Scholar] [CrossRef]
- Delves-Broughton, J.; Blackburn, P.; Evans, R.J.; Hugenholtz, J. Applications of the bacteriocin, nisin. Antonie Leeuwenhoek 1996, 69, 193–202. [Google Scholar] [CrossRef]
- Cleveland, J.; Montville, T.J.; Nes, I.F.; Chikindas, M.L. Bacteriocins: Safe, natural antimicrobials for food preservation. Int. J. Food Microbiol. 2001, 71, 1–20. [Google Scholar] [CrossRef]
- Chikindas, M.L.; Garcia-Garcera, M.J.; Driessen, A.J.; Ledeboer, A.M.; Nissen-Meyer, J.; Nes, I.F.; Abee, T.; Konings, W.N.; Venema, G. Pediocin pa-1, a bacteriocin from Pediococcus acidilactici pac1.0, forms hydrophilic pores in the cytoplasmic membrane of target cells. Appl. Environ. Microbiol. 1993, 59, 3577–3584. [Google Scholar] [CrossRef] [PubMed] [Green Version]
- Bédard, F.; Hammami, R.; Zirah, S.; Rebuffat, S.; Fliss, I.; Biron, E. Synthesis, antimicrobial activity and conformational analysis of the class iia bacteriocin pediocin PA-1 and analogs thereof. Sci. Rep. 2018, 8, 9029. [Google Scholar] [CrossRef] [PubMed] [Green Version]
- Bédard, F.; Fliss, I.; Biron, E. Structure-activity relationships of the bacteriocin bactofencin a and its interaction with the bacterial membrane. ACS Infect. Dis. 2019, 5, 199–207. [Google Scholar] [CrossRef] [PubMed] [Green Version]
- Guinane, C.; Lawton, E.; O’Connor, P.; O’Sullivan, O.; Hill, C.; Ross, R.; Cotter, P. The bacteriocin bactofencin a subtly modulates gut microbial populations. Anaerobe 2016, 40, 41–49. [Google Scholar] [CrossRef] [PubMed]
- O’Shea, E.F.; O’Connor, P.M.; O’Sullivan, O.; Cotter, P.D.; Ross, R.P.; Hill, C. Bactofencin a, a new type of cationic bacteriocin with unusual immunity. mBio 2013, 4, e00498-13. [Google Scholar] [CrossRef] [PubMed] [Green Version]
- Schaefer, L.; Auchtung, T.A.; Hermans, K.E.; Whitehead, D.; Borhan, B.; Britton, R.A. The antimicrobial compound reuterin (3-hydroxypropionaldehyde) induces oxidative stress via interaction with thiol groups. Microbiology 2010, 156, 1589–1599. [Google Scholar] [CrossRef] [PubMed] [Green Version]
- Talarico, T.L.; Dobrogosz, W.J. Chemical characterization of an antimicrobial substance produced by Lactobacillus reuteri. Antimicrob. Agents Chemother. 1989, 33, 674–679. [Google Scholar] [CrossRef] [Green Version]
- Vollenweider, S.; Grassi, G.; König, I.; Puhan, Z. Purification and structural characterization of 3-hydroxypropionaldehyde and its derivatives. J. Agric. Food Chem. 2003, 51, 3287–3293. [Google Scholar] [CrossRef] [PubMed]
- Axelsson, L.T.; Chung, T.C.; Dobrogosz, W.J.; Lindgren, S.E. Production of a broad spectrum antimicrobial substance by Lactobacillus reuteri. Microb. Ecol. Health Dis. 1989, 2, 131–136. [Google Scholar]
- Cleusix, V.; Lacroix, C.; Vollenweider, S.; Duboux, M.; Le Blay, G. Inhibitory activity spectrum of reuterin produced by Lactobacillus reuteri against intestinal bacteria. BMC Microbiol. 2007, 7, 101. [Google Scholar] [CrossRef] [PubMed] [Green Version]
- Erskine, R.J.; Walker, R.D.; Bolin, C.A.; Bartlett, P.C.; White, D.G. Trends in antibacterial susceptibility of mastitis pathogens during a seven-year period. J. Dairy Sci. 2002, 85, 1111–1118. [Google Scholar] [CrossRef]
- Güler, L.; Ok, U.; Gündüz, K.; Gülcü, Y.; Hadimli, H.H. Antimicrobial susceptibility and coagulase gene typing of Staphylococcus aureus isolated from bovine clinical mastitis cases in turkey. J. Dairy Sci. 2005, 88, 3149–3154. [Google Scholar] [CrossRef] [Green Version]
- Saini, V.; McClure, J.T.; Léger, D.; Dufour, S.; Sheldon, A.G.; Scholl, D.T.; Barkema, H.W. Antimicrobial use on canadian dairy farms. J. Dairy Sci. 2012, 95, 1209–1221. [Google Scholar] [CrossRef] [PubMed]
- Mello, P.L.; Pinheiro, L.; Martins, L.A.; Brito, M.; Ribeiro de Souza da Cunha, M.L. Short communication: B-lactam resistance and vancomycin heteroresistance in Staphylococcus spp. Isolated from bovine subclinical mastitis. J. Dairy Sci. 2017, 100, 6567–6571. [Google Scholar] [CrossRef] [PubMed]
- Cheng, J.; Qu, W.; Barkema, H.W.; Nobrega, D.B.; Gao, J.; Liu, G.; De Buck, J.; Kastelic, J.P.; Sun, H.; Han, B. Antimicrobial resistance profiles of 5 common bovine mastitis pathogens in large chinese dairy herds. J. Dairy Sci. 2019, 102, 2416–2426. [Google Scholar] [CrossRef] [PubMed] [Green Version]
- Jamali, H.; Radmehr, B.; Ismail, S. Short communication: Prevalence and antibiotic resistance of Staphylococcus aureus isolated from bovine clinical mastitis. J. Dairy Sci. 2014, 97, 2226–2230. [Google Scholar] [CrossRef] [PubMed]
- Makovec, J.A.; Ruegg, P.L. Antimicrobial resistance of bacteria isolated from dairy cow milk samples submitted for bacterial culture: 8905 samples (1994–2001). J. Am. Vet. Med. Assoc. 2003, 222, 1582–1589. [Google Scholar] [CrossRef] [PubMed]
- Thornsberry, C.; Burton, P.J.; Yee, Y.C.; Watts, J.L.; Yancey, R.J., Jr. The activity of a combination of penicillin and novobiocin against bovine mastitis pathogens: Development of a disk diffusion test. J. Dairy Sci. 1997, 80, 413–421. [Google Scholar] [CrossRef]
- Marimani, M. Chapter 2—Combination therapy against multidrug resistance. In Combination Therapy against Multidrug Resistance; Wani, M.Y., Ahmad, A., Eds.; Academic Press: Cambridge, MA, USA, 2020; pp. 39–64. [Google Scholar]
- Oliver, S.P.; Murinda, S.E. Antimicrobial resistance of mastitis pathogens. Vet. Clin. N. Am. Food Anim. 2012, 28, 165–185. [Google Scholar] [CrossRef] [PubMed]
- Stokes, H.W.; Gillings, M.R. Gene flow, mobile genetic elements and the recruitment of antibiotic resistance genes into gram-negative pathogens. FEMS Microbiol. Rev. 2011, 35, 790–819. [Google Scholar] [CrossRef]
- Munita, J.M.; Arias, C.A. Mechanisms of antibiotic resistance. Microbiol. Spectr. 2016, 4, 481–511. [Google Scholar] [CrossRef] [PubMed] [Green Version]
- Barkema, H.W.; Schukken, Y.H.; Zadoks, R.N. Invited review: The role of cow, pathogen, and treatment regimen in the therapeutic success of bovine Staphylococcus aureus mastitis. J. Dairy Sci. 2006, 89, 1877–1895. [Google Scholar] [CrossRef] [Green Version]
- Manyi-Loh, C.; Mamphweli, S.; Meyer, E.; Okoh, A. Antibiotic use in agriculture and its consequential resistance in environmental sources: Potential public health implications. Molecules 2018, 23, 795. [Google Scholar] [CrossRef] [PubMed] [Green Version]
- Singer, A.C.; Shaw, H.; Rhodes, V.; Hart, A. Review of antimicrobial resistance in the environment and its relevance to environmental regulators. Front. Microbiol. 2016, 7, 1728. [Google Scholar] [CrossRef] [PubMed] [Green Version]
- Severina, E.; Severin, A.; Tomasz, A. Antibacterial efficacy of nisin against multidrug-resistant grampositive pathogens. J. Antimicrob. Chemother. 1998, 41, 341–347. [Google Scholar] [CrossRef] [PubMed]
- Kitazaki, K.; Koga, S.; Nagatoshi, K.; Kuwano, K.; Zendo, T.; Nakayama, J.; Sonomoto, K.; Ano, H.; Katamoto, H. In vitro synergistic activities of cefazolin and nisin a against mastitis pathogens. J. Vet. Med. Sci. 2017, 79, 1472–1479. [Google Scholar] [CrossRef] [Green Version]
- Castelani, L.; Arcaro, J.R.P.; Braga, J.E.P.; Bosso, A.S.; Moura, Q.; Esposito, F.; Sauter, I.P.; Cortez, M.; Lincopan, N. Short communication: Activity of nisin, lipid bilayer fragments and cationic nisin-lipid nanoparticles against multidrug-resistant Staphylococcus spp. Isolated from bovine mastitis. J. Dairy Sci. 2019, 102, 678–683. [Google Scholar] [CrossRef] [PubMed] [Green Version]
- Dosler, S.; Gerceker, A.A. In vitro activities of nisin alone or in combination with vancomycin and ciprofloxacin against methicillin-resistant and methicillin-susceptible Staphylococcus aureus strains. Chemotherapy 2011, 57, 511–516. [Google Scholar] [CrossRef] [PubMed]
- Angelopoulou, A.; Field, D.; Pérez-Ibarreche, M.; Warda, A.K.; Hill, C.; Ross, R.P. Vancomycin and nisin a are effective against biofilms of multi-drug resistant Staphylococcus aureus isolates from human milk. PLoS ONE 2020, 15, e0233284. [Google Scholar] [CrossRef] [PubMed]
- Chen, C.N.; Sung, H.W.; Liang, H.F.; Chang, W.H. Feasibility study using a natural compound (reuterin) produced by Lactobacillus reuteri in sterilizing and crosslinking biological tissues. J. Biomed. Mater. Res. 2002, 61, 360–369. [Google Scholar] [CrossRef] [PubMed]
- Arqués, J.L.; Fernández, J.; Gaya, P.; Nuñez, M.; Rodríguez, E.; Medina, M. Antimicrobial activity of reuterin in combination with nisin against food-borne pathogens. Int. J. Food Microbiol. 2004, 95, 225–229. [Google Scholar] [CrossRef] [PubMed]
- Asare, P.T.; Greppi, A.; Stettler, M.; Schwab, C.; Stevens, M.J.A.; Lacroix, C. Decontamination of minimally-processed fresh lettuce using reuterin produced by Lactobacillus reuteri. Front. Microbiol. 2018, 9, 1421. [Google Scholar] [CrossRef]
- Rodríguez, J.M.; Martínez, M.I.; Kok, J. Pediocin pa-1, a wide-spectrum bacteriocin from lactic acid bacteria. Crit. Rev. Food Sci. Nutr. 2002, 42, 91–121. [Google Scholar] [CrossRef] [PubMed] [Green Version]
- Cintas, L.M.; Casaus, P.; Fernández, M.F.; Hernández, P.E. Comparative antimicrobial activity of enterocin l50, pediocin pa-1, nisin a and lactocin s against spoilage and foodborne pathogenic bacteria. Food Microbiol. 1998, 15, 289–298. [Google Scholar] [CrossRef]
- Héchard, Y.; Pelletier, C.; Cenatiempo, Y.; Frère, J. Analysis of sigma(54)-dependent genes in Enterococcus faecalis: A mannose pts permease (eii(man)) is involved in sensitivity to a bacteriocin, mesentericin y105. Microbiology 2001, 147, 1575–1580. [Google Scholar] [CrossRef] [PubMed] [Green Version]
- Gravesen, A.; Ramnath, M.; Rechinger, K.B.; Andersen, N.; Jänsch, L.; Héchard, Y.; Hastings, J.W.; Knøchel, S. High-level resistance to class iia bacteriocins is associated with one general mechanism in Listeria monocytogenes. Microbiology 2002, 148, 2361–2369. [Google Scholar] [CrossRef] [PubMed] [Green Version]
- Saier, M.H., Jr. The bacterial phosphotransferase system: New frontiers 50 years after its discovery. J. Mol. Microbiol. Biotechnol. 2015, 25, 73–78. [Google Scholar] [CrossRef] [Green Version]
- Ramnath, M.; Beukes, M.; Tamura, K.; Hastings, J.W. Absence of a putative mannose-specific phosphotransferase system enzyme iiab component in a leucocin a-resistant strain of Listeria monocytogenes, as shown by two-dimensional sodium dodecyl sulfate-polyacrylamide gel electrophoresis. Appl. Environ. Microbiol. 2000, 66, 3098–3101. [Google Scholar] [CrossRef] [Green Version]
- Reyher, K.K.; Dufour, S.; Barkema, H.W.; Des Coteaux, L.; Devries, T.J.; Dohoo, I.R.; Keefe, G.P.; Roy, J.P.; Scholl, D.T. The national cohort of dairy farms—A data collection platform for mastitis research in canada. J. Dairy Sci. 2011, 94, 1616–1626. [Google Scholar] [CrossRef] [PubMed] [Green Version]
- Gough, R.; Gomez-Sala, B.; O’Connor, P.M.; Rea, M.C.; Miao, S.; Hill, C.; Brodkorb, A. A simple method for the purification of nisin. Probiotics Antimicrob. Proteins 2017, 9, 363–369. [Google Scholar] [CrossRef] [PubMed]
- Vimont, A.; Fernandez, B.; Ahmed, G.; Fortin, H.P.; Fliss, I. Quantitative antifungal activity of reuterin against food isolates of yeasts and moulds and its potential application in yogurt. Int. J. Food Microbiol. 2019, 289, 182–188. [Google Scholar] [CrossRef] [PubMed]
- Tagg, J.R.; Dajani, A.S.; Wannamaker, L.W. Bacteriocins of gram-positive bacteria. Bacteriol. Rev. 1976, 40, 722–756. [Google Scholar] [CrossRef] [PubMed]
- Clinical and Laboratory Standard Institute (CLSI) Performance Standards for Antimicrobial Susceptibility Testing Twenty-Fifth Informational Supplement. 2018. Available online: https://clsi.org/media/3481/m100ed30_sample.pdf (accessed on 3 November 2021).
- Pankey, G.A.; Sabath, L.D. Clinical relevance of bacteriostatic versus bactericidal mechanisms of action in the treatment of gram-positive bacterial infections. Clin. Infect. Dis. 2004, 38, 864–870. [Google Scholar] [CrossRef] [PubMed] [Green Version]

| S. aureus (n = 19) | S. dysgalactiae (n = 17) | S. uberis (n = 19) | |
|---|---|---|---|
| No. of Resistant Strains (%) | |||
| PEN | 9 (50) | 10 (59) | 9 (50) |
| P/N | 1 (6) | 3 (18) | 5 (28) |
| AMC | 5 (28) | 8 (47) | 5 (28) |
| VAN | 2 (11) | 2 (12) | 4 (22) |
| CEF | 7 (39) | 9 (53) | 7 (39) |
| CTX | 7 (39) | 9 (53) | 6 (33) |
| FOX | 7 (39) | 10 (59) | 6 (33) |
| ERY | 3 (17) | 4 (24) | 5 (28) |
| CHL | 5 (28) | 6 (35) | 5 (28) |
| CIP | 2 (11) | 0 (0) | 0 (0) |
| CC | 0 (0) | 0 (0) | 0 (0) |
| TET | 3 (17) | 5 (29) | 2 (11) |
| KAN | 5 (28) | - | - |
| GEN | 4 (22) | - | - |
| MDR | 6 (32) | 8 (47) | 7 (37) |
| Species (n) | AMR | No. | MIC50 | MIC Interval | MBC50 | MBC Interval | Ratio | N |
|---|---|---|---|---|---|---|---|---|
| S. aureus (19) | 19 | 7.8 | 2.0–≥100 | 15.6 | 3.9–≥100 | 2 | 1 | |
| 0 | 9 | 7.8 | 2.0–15.6 | 15.6 | 3.9–31.2 | 2 | 0 | |
| 1 or 2 | 4 | 7.8 | 3.9–7.8 | 15.6 | 7.8–31.2 | 2 | 0 | |
| ≥3 | 6 | 7.8 | 3.9–≥100 | 15.6 | 7.8–≥100 | 2 | 1 | |
| S. dysgalactiae (17) | 17 | 7.8 | 1.0–≥100 | 15.6 | 1.0–≥100 | 2 | 2 | |
| 0 | 4 | 7.8 | 7.8–15.6 | 15.6 | 7.8–31.2 | 2 | 0 | |
| 1 or 2 | 5 | 7.8 | 7.8–15.6 | 7.8 | 7.8–15.6 | 1 | 0 | |
| ≥3 | 8 | 15.6 | 1.0–≥100 | 15.6 | 1.0–≥100 | 1 | 2 | |
| S. uberis(19) | 19 | 3.9 | ≤1.0–≥100 | 7.8 | ≤1.0–≥100 | 2 | 4 | |
| 0 | 8 | 3.9 | ≤1.0–7.8 | 15.6 | 2.0–15.6 | 4 | 0 | |
| 1 or 2 | 4 | 1.0 | ≤1.0–3.9 | 2.0 | ≤1.0–3.9 | 2 | 0 | |
| ≥3 | 7 | ≥100 | 3.9–≥100 | ≥100 | 3.9–≥100 | N/D | 4 |
| Species (n) | AMR | No. | MIC50 | MIC Interval | MBC50 | MBC Interval | Ratio | N |
|---|---|---|---|---|---|---|---|---|
| S. aureus (19) | 19 | 140 | 70–560 | 1120 | 560–2240 | 8 | 0 | |
| 0 | 9 | 70 | 70–560 | 1120 | 560–2240 | 16 | 0 | |
| 1 or 2 | 4 | 140 | 140 | 1120 | 560–1120 | 8 | 0 | |
| ≥3 | 6 | 280 | 70–560 | 1120 | 560–2240 | 4 | 0 | |
| S. dysgalactiae (17) | 17 | 140 | 70–560 | 280 | 140–2240 | 2 | 0 | |
| 0 | 4 | 140 | 70–560 | 560 | 140–1120 | 4 | 0 | |
| 1 or 2 | 5 | 140 | 140 | 140 | 140–2240 | 1 | 0 | |
| ≥3 | 8 | 280 | 140–560 | 560 | 140–2240 | 2 | 0 | |
| S. uberis (19) | 19 | 280 | 140–560 | 280 | 280–2240 | 1 | 0 | |
| 0 | 8 | 280 | 140–280 | 280 | 280–560 | 1 | 0 | |
| 1 or 2 | 4 | 280 | 140–280 | 280 | 280–560 | 1 | 0 | |
| ≥3 | 7 | 280 | 140–560 | 1120 | 280–2240 | 4 | 0 |
| Species (n) | AMR | No. | MIC50 | MIC Interval | MBC Interval | Ratio | N | |
|---|---|---|---|---|---|---|---|---|
| S. aureus (19) | 19 | 3.9 | 2.0–≥250 | 31.2 | 15.6–≥250 | 8 | 1 | |
| 0 | 9 | 2.0 | 2.0–7.8 | 31.2 | 15.6–250 | 16 | 0 | |
| 1 or 2 | 4 | 3.9 | 3.9–15.6 | 62.5 | 31.2–125 | 16 | 0 | |
| ≥3 | 6 | 7.8 | 2.0–≥250 | 62.5 | 31.2–≥250 | 8 | 1 | |
| S. dysgalactiae (17) | 17 | 62.5 | 7.8–62.5 | 125 | 31.2–125 | 2 | 0 | |
| 0 | 4 | 62.5 | 31.2–62.5 | 125 | 125 | 2 | 0 | |
| 1 or 2 | 5 | 62.5 | 62.5 | 125 | 125 | 2 | 0 | |
| ≥3 | 8 | 62.5 | 7.8–62.5 | 125 | 31.2–125 | 2 | 0 | |
| S. uberis (19) | 19 | 15.6 | 3.9–62.5 | 31.2 | 15.6–62.5 | 2 | 0 | |
| 0 | 8 | 15.6 | 3.9–15.6 | 31.2 | 15.6–62.5 | 2 | 0 | |
| 1 or 2 | 4 | 15.6 | 15.6 | 31.2 | 31.2–62.5 | 2 | 0 | |
| ≥3 | 7 | 15.6 | 7.8–62.5 | 31.2 | 31.2–62.5 | 2 | 0 |
Publisher’s Note: MDPI stays neutral with regard to jurisdictional claims in published maps and institutional affiliations. |
© 2021 by the authors. Licensee MDPI, Basel, Switzerland. This article is an open access article distributed under the terms and conditions of the Creative Commons Attribution (CC BY) license (https://creativecommons.org/licenses/by/4.0/).
Share and Cite
Bennett, S.; Ben Said, L.; Lacasse, P.; Malouin, F.; Fliss, I. Susceptibility to Nisin, Bactofencin, Pediocin and Reuterin of Multidrug Resistant Staphylococcus aureus, Streptococcus dysgalactiae and Streptococcus uberis Causing Bovine Mastitis. Antibiotics 2021, 10, 1418. https://doi.org/10.3390/antibiotics10111418
Bennett S, Ben Said L, Lacasse P, Malouin F, Fliss I. Susceptibility to Nisin, Bactofencin, Pediocin and Reuterin of Multidrug Resistant Staphylococcus aureus, Streptococcus dysgalactiae and Streptococcus uberis Causing Bovine Mastitis. Antibiotics. 2021; 10(11):1418. https://doi.org/10.3390/antibiotics10111418
Chicago/Turabian StyleBennett, Samantha, Laila Ben Said, Pierre Lacasse, François Malouin, and Ismail Fliss. 2021. "Susceptibility to Nisin, Bactofencin, Pediocin and Reuterin of Multidrug Resistant Staphylococcus aureus, Streptococcus dysgalactiae and Streptococcus uberis Causing Bovine Mastitis" Antibiotics 10, no. 11: 1418. https://doi.org/10.3390/antibiotics10111418
APA StyleBennett, S., Ben Said, L., Lacasse, P., Malouin, F., & Fliss, I. (2021). Susceptibility to Nisin, Bactofencin, Pediocin and Reuterin of Multidrug Resistant Staphylococcus aureus, Streptococcus dysgalactiae and Streptococcus uberis Causing Bovine Mastitis. Antibiotics, 10(11), 1418. https://doi.org/10.3390/antibiotics10111418

